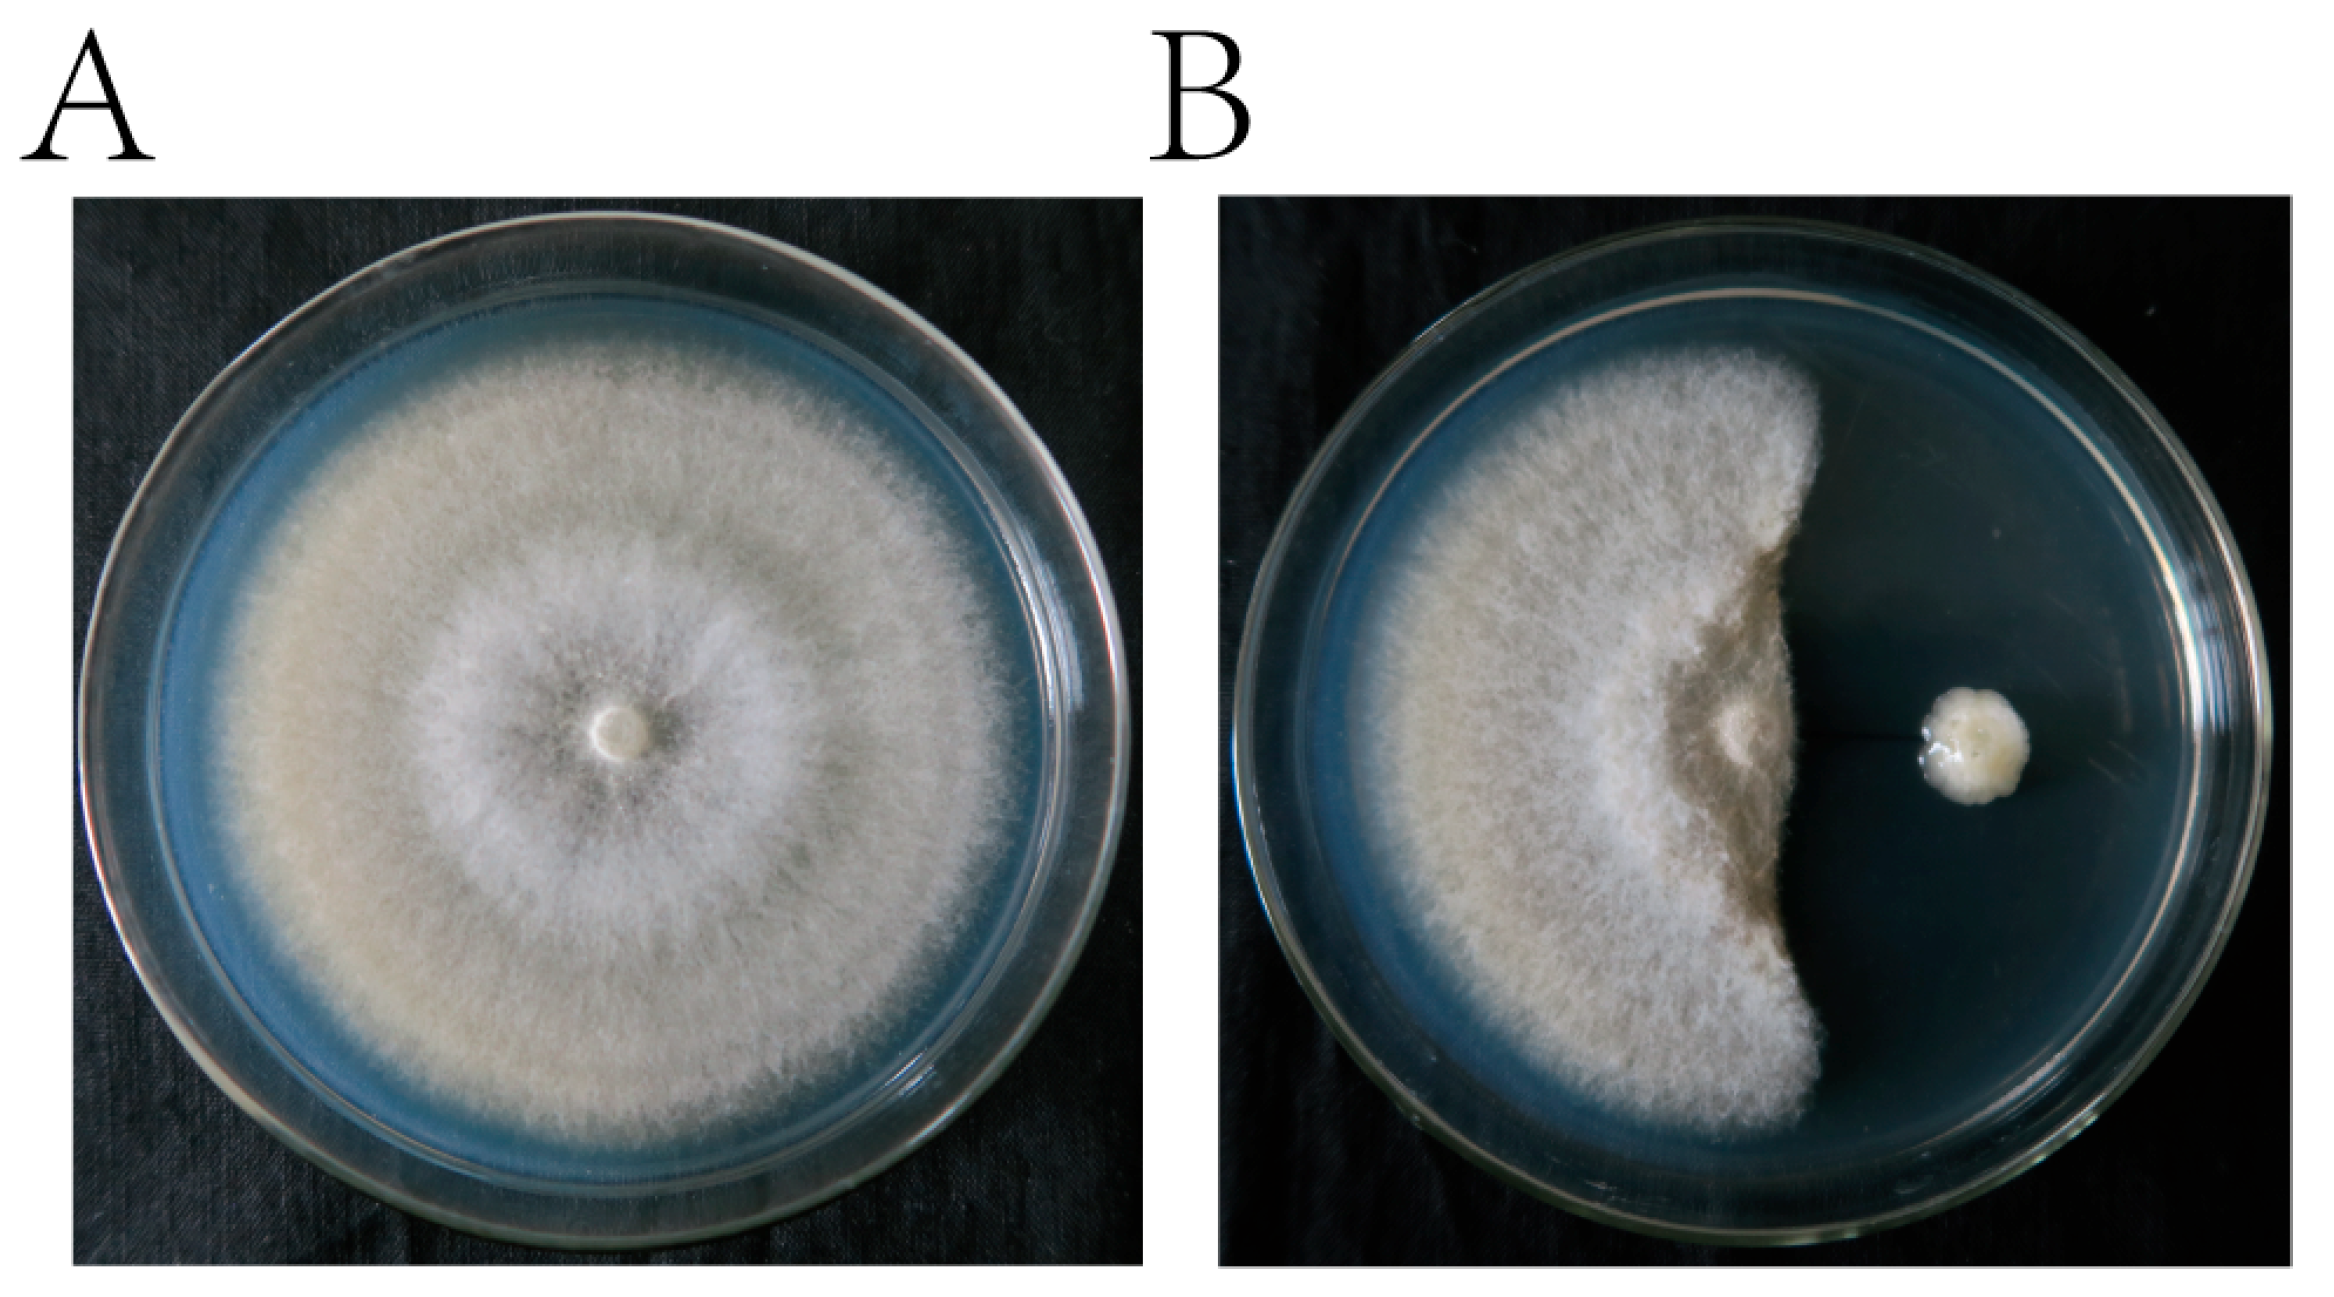

Characterization of Antagonistic Bacteria Paenibacillus polymyxa ZYPP18 and the Effects on Plant Growth
Abstract
1. Introduction
2. Results
2.1. Bacterium Identification
2.2. Antagonistic Activity
2.2.1. Inhibition Effect on R. cerealis
2.2.2. Disease Inhibition Effect on Detached Leaves
2.2.3. Detection of Genes Related to Antibacterial Substance Synthesis
2.3. Plant Growth Promotion
2.3.1. Growth–Promoting Effect on Wheat Seedlings
2.3.2. Phosphorus Solubilization Activity
2.3.3. IAA Production
2.4. Control Effect of ZYPP18 on Wheat Sheath Blight in Pot and Field Experiments
3. Discussion
4. Materials and Methods
4.1. Isolation and Identification of the Strain
4.2. In Vitro Antagonism Test against R. cerealis
4.2.1. Antimicrobial Activity of Antagonistic Bacteria
4.2.2. Antimicrobial Activity of Fermentation Filtrate
4.2.3. Detached Leaves Experiment
4.2.4. Detection of the Genes Related to Antimicrobial Substance Synthesis
4.3. Growth–Promoting Properties Test
4.3.1. Plant Growth–Promoting Experiments
4.3.2. Phosphate Solubilization Assay
4.3.3. IAA Production Assay
4.3.4. IAA Gene Detection
4.4. In Vivo Plant Experiment
4.4.1. Pot Experiment
4.4.2. Field Experiment
4.5. Statistical Analysis
Author Contributions
Funding
Data Availability Statement
Conflicts of Interest
References
- Rai, S.; Omar, A.F.; Rehan, M.; Al–Turki, A.; Sagar, A.; Ilyas, N.; Sayyed, R.Z.; Hasanuzzaman, M. Crop microbiome: Their role and advances in molecular and omic techniques for the sustenance of agriculture. Planta 2022, 257, 27. [Google Scholar] [CrossRef] [PubMed]
- Bhattacharyya, P.N.; Jha, D.K. Plant growth–promoting rhizobacteria (PGPR): Emergence in agriculture. World J. Microbiol. Biotechnol. 2012, 28, 1327–1350. [Google Scholar] [CrossRef] [PubMed]
- Bhat, M.A.; Mishra, A.K.; Jan, S.; Bhat, M.A.; Kamal, M.A.; Rahman, S.; Shah, A.A.; Jan, A.T. Plant Growth Promoting Rhizobacteria in Plant Health: A Perspective Study of the Underground Interaction. Plants 2023, 12, 629. [Google Scholar] [CrossRef] [PubMed]
- de Andrade, L.A.; Santos, C.H.B.; Frezarin, E.T.; Sales, L.R.; Rigobelo, E.C. Plant Growth–Promoting Rhizobacteria for Sustainable Agricultural Production. Microorganisms 2023, 11, 1088. [Google Scholar] [CrossRef]
- Rodriguez, H.; Fraga, R. Phosphate solubilizing bacteria and their role in plant growth promotion. Biotechnol. Adv. 1999, 17, 319–339. [Google Scholar] [CrossRef]
- Spaepen, S.; Vanderleyden, J.; Remans, R. Indole–3–acetic acid in microbial and microorganism–plant signaling. Fems Microbiol. Rev. 2007, 31, 425–448. [Google Scholar] [CrossRef]
- Glick, B.R.; Cheng, Z.; Czarny, J.; Duan, J. Promotion of plant growth by ACC deaminase–producing soil bacteria. New Perspect. Approaches Plant Growth–Promot. Rhizobacteria Res. 2007, 119, 329–339. [Google Scholar] [CrossRef]
- Compant, S.; Duffy, B.; Nowak, J.; Clément, C.; Barka, E.A. Use of plant growth–promoting bacteria for biocontrol of plant diseases: Principles, mechanisms of action, and future prospects. Appl. Environ. Microbiol 2005, 71, 4951–4959. [Google Scholar] [CrossRef]
- Lugtenberg, B.; Kamilova, F. Plant–growth–promoting rhizobacteria. Annu. Rev. Microbiol. 2009, 63, 541–556. [Google Scholar] [CrossRef]
- Beneduzi, A.; Ambrosini, A.; Passaglia, L.M.P. Plant growth–promoting rhizobacteria (PGPR): Their potential as antagonists and biocontrol agents. Genet. Mol. Biol. 2012, 35, 1044–1051. [Google Scholar] [CrossRef]
- Hlaváčová, M.; Klem, K.; Rapantová, B.; Novotná, K.; Urban, O.; Hlavinka, P.; Trnka, M. Interactive effects of high temperature and drought stress during stem elongation, anthesis and early grain filling on the yield formation and photosynthesis of winter wheat. Field Crops Res. 2018, 221, 182–195. [Google Scholar] [CrossRef]
- Hamada, M.S.; Yin, Y.; Chen, H.; Ma, Z. The escalating threat of Rhizoctonia cerealis, the causal agent of sharp eyespot in wheat. Pest Manag. Sci. 2011, 67, 1411–1419. [Google Scholar] [CrossRef]
- McMillan, V.E.; Canning, G.; Moughan, J.; White, R.P.; Gutteridge, R.J.; Hammond–Kosack, K.E. Exploring the resilience of wheat crops grown in short rotations through minimising the build–up of an important soil–borne fungal pathogen. Sci. Rep. 2018, 8, 9550. [Google Scholar] [CrossRef] [PubMed]
- He, D.C.; He, M.H.; Amalin, D.M.; Liu, W.; Alvindia, D.G.; Zhan, J. Biological control of plant diseases: An evolutionary and eco–economic consideration. Pathogens 2021, 10, 1311. [Google Scholar] [CrossRef] [PubMed]
- Anand, R.; Grayston, S.; Chanway, C. N–2–fixation and seedling growth promotion of lodgepole pine by endophytic Paenibacillus polymyxa. Microb. Ecol. 2013, 66, 369–374. [Google Scholar] [CrossRef]
- Grady, E.N.; MacDonald, J.; Liu, L.; Richman, A.; Yuan, Z.C. Current knowledge and perspectives of Paenibacillus: A Review. Microb. Cell Factories 2016, 15, 203. [Google Scholar] [CrossRef] [PubMed]
- Langendries, S.; Goormachtig, S. Paenibacillus Polymyxa, a jack of all trades. Environ. Microbiol. 2021, 23, 5659–5669. [Google Scholar] [CrossRef]
- Lee, B.; Farag, M.A.; Park, H.B.; Kloepper, J.W.; Lee, S.H.; Ryu, C.M. Induced resistance by a long–chain bacterial volatile: Elicitation of plant systemic defense by a C13 volatile produced by Paenibacillus polymyxa. PLoS ONE 2012, 7, e48744. [Google Scholar] [CrossRef] [PubMed]
- Shaheen, M.; Li, J.; Ross, A.C.; Vederas, J.C.; Jensen, S.E. Paenibacillus polymyxa PKB1 produces variants of polymyxin B–Type antibiotics. Chem. Biol. 2011, 18, 1640–1648. [Google Scholar] [CrossRef] [PubMed]
- Kim, J.F.; Jeong, H.; Park, S.Y.; Kim, S.B.; Park, Y.K.; Choi, S.K.; Ryu, C.M.; Hur, C.G.; Ghim, S.Y.; Oh, T.K.; et al. Genome sequence of the polymyxin–producing plant–probiotic rhizobacterium Paenibacillus polymyxa E681. J. Bacteriol. 2010, 192, 6103–6104. [Google Scholar] [CrossRef]
- Eastman, A.W.; Heinrichs, D.E.; Yuan, Z.C. Comparative and genetic analysis of the four sequenced Paenibacillus polymyxa genomes reveals a diverse metabolism and conservation of genes relevant to plant–growth promotion and competitiveness. BMC Genom. 2014, 15, 851. [Google Scholar] [CrossRef] [PubMed]
- Liu, H.; Wang, J.; Sun, H.; Han, X.; Peng, Y.; Liu, J.; Liu, K.; Ding, Y.; Wang, C.; Du, B. Transcriptome profilesreveal the growth–promoting mechanisms of Paenibacillus Polymyxa YC0136 on tobacco (Nicotiana Tabacum L.). Front. Microbiol. 2020, 11, 584174. [Google Scholar] [CrossRef] [PubMed]
- Ogbe, A.A.; Gupta, S.; Stirk, W.A.; Finnie, J.F.; Van Staden, J. Growth–Promoting Characteristics of Fungal and Bacterial Endophytes Isolated from a Drought–Tolerant Mint Species Endostemon obtusifolius (E. Mey. ex Benth.) NE. Br. Plants 2023, 12, 638. [Google Scholar] [CrossRef] [PubMed]
- He, Z.; Kisla, D.; Zhang, L.; Yuan, C.; Green–Church, K.B.; Yousef, A.E. Isolation and identification of a Paenibacillus polymyxa strain that coproduces a novel lantibiotic and polymyxin. Appl. Environ. Microbiol. 2007, 73, 168–178. [Google Scholar] [CrossRef]
- Raza, W.; Yang, X.; Wu, H.; Wang, Y.; Xu, Y.; Shen, Q. Isolation and characterisation of fusaricidin–type compound–producing strain of Paenibacillus polymyxa SQR–21 active against Fusarium oxysporum f.sp. nevium. Eur. J. Plant Pathol. 2009, 125, 471–483. [Google Scholar] [CrossRef]
- Cho, K.M.; Hong, S.Y.; Lee, S.M.; Kim, Y.H.; Kahng, G.G.; Kim, H.; Yun, H.D. A cel44C–man26A gene of endophytic Paenibacillus polymyxa GS01 has multi–glycosyl hydrolases in two catalytic domains. Appl. Microbiol. Biotechnol. 2006, 73, 618–630. [Google Scholar] [CrossRef]
- Martin, N.I.; Hu, H.; Moake, M.M.; Churey, J.J.; Whittal, R.; Worobo, R.W.; Vederas, J.C. Isolation, structural characterization, and properties of mattacin (polymyxin M), a cyclic peptide antibiotic produced by Paenibacillus kobensis M. J. Biol. Chem. 2003, 278, 13124–13132. [Google Scholar] [CrossRef]
- Weselowski, B.; Nathoo, N.; Eastman, A.W.; MacDonald, J.; Yuan, Z.C. Isolation, identification and characterization of Paenibacillus polymyxa CR1 with potentials for biopesticide, biofertilization, biomass degradation and biofuel production. BMC Microbiol. 2016, 16, 244. [Google Scholar] [CrossRef]
- de Souza Vandenberghe, L.P.; Garcia, L.M.B.; Rodrigues, C.; Camara, M.C.; de Melo Pereira, G.V.; de Oliveira, J.; Soccol, C.R. Potential applications of plant probiotic microorganisms in agriculture and forestry. AIMS Microbiol. 2017, 3, 629–648. [Google Scholar] [CrossRef]
- Burketova, L.; Trda, L.; Ott, P.G.; Valentova, O. Bio–based resistance inducers for sustainable plant protection against pathogens. Biotechnol. Adv. 2015, 33, 994–1004. [Google Scholar] [CrossRef]
- Li, J.; Zhao, Q.; Wuriyanghan, H.; Yang, C. Biocontrol Bacteria Strains Y4 and Y8 Alleviate Tobacco Bacterial Wilt Disease by Altering Their Rhizosphere Soil Bacteria Community. Rhizosphere 2021, 19, 100390. [Google Scholar] [CrossRef]
- Mohite, B. Isolation and characterization of indole acetic acid (IAA) producing bacteria from rhizospheric soil and its effect on plant growth. J. Soil Sci. Plant Nutr. 2013, 13, 638–649. [Google Scholar] [CrossRef]
- Bal, H.B.; Das, S.; Dangar, T.K.; Adhya, T.K. ACC deaminase and IAA producing growth promoting bacteria from the rhizosphere soil of tropical rice plants. J. Basic Microbiol. 2013, 53, 972–984. [Google Scholar] [CrossRef] [PubMed]
- Khan, Z.; Son, S.H.; Akhtar, J.; Gautam, N.K.; Kim, Y.H. Plant growth–promoting rhizobacterium (Paenibacillus polymyxa) induced systemic resistance in tomato (Lycopersicon esculentum) against root–knot nematode (Meloidogyne incognita). Indian J. Agric. Sci. 2012, 82, 603–607. [Google Scholar]
- Mohamed, I.; Eid, K.E.; Abbas, M.H.H.; Salem, A.A.; Ahmed, N.; Ali, M.; Shah, G.M.; Fang, C. Use of plant growth promoting Rhizobacteria (PGPR) and mycorrhizae to improve the growth and nutrient utilization of common bean in a soil infected with white rot fungi. Ecotoxicol. Environ. Saf. 2019, 171, 539–548. [Google Scholar] [CrossRef]
- Han, H.S.; Supanjani; Lee, K.D. Effect of co–inoculation with phosphate and potassium solubilizing bacteria on mineral uptake and growth of pepper and cucumber. Plant Soil Environ. 2006, 52, 130–136. [Google Scholar] [CrossRef]
- Chen, B.; Han, H.; Hou, J.; Bao, F.; Tan, H.; Lou, X.; Wang, G.; Zhao, F. Control of Maize Sheath Blight and Elicit Induced Systemic Resistance Using Paenibacillus polymyxa Strain SF05. Microorganisms 2022, 10, 1318. [Google Scholar] [CrossRef]
- Khan, N.; Zandi, P.; Ali, S.; Mehmood, A.; Adnan, S.M. Impact of salicylic acid and PGPR on the drought tolerance and phytoremediation potential of Helianthus annus. Front. Microbiol. 2018, 9, 2507. [Google Scholar] [CrossRef]
- Yi, W.; Chen, C.; Gan, X. Active metabolites from the endophyte Paenibacillus polymyxa Y–1 of Dendrobium nobile for the control of rice bacterial diseases. Front. Chem. 2022, 10, 879724. [Google Scholar] [CrossRef]
- Daud, N.S.; Rosli, M.A.; Azam, Z.M.; Othman, N.Z.; Sarmidi, M.R. Paenibacillus polymyxa bioactive compounds for agricultural and biotechnological applications. Biocatal. Agric. Biotechnol. 2019, 18, 101092. [Google Scholar] [CrossRef]
- Zhai, Y.; Zhu, J.X.; Tan, T.M.; Xu, J.P.; Shen, A.R.; Yang, X.B.; Li, J.L.; Zeng, L.B.; Wei, L. Isolation and characterization of antagonistic Paenibacillus polymyxa HX–140 and its biocontrol potential against Fusarium wilt of cucumber seedlings. BMC Microbiol. 2021, 21, 75. [Google Scholar] [CrossRef]
- Yuan, H.; Yuan, M.; Shi, B.; Wang, Z.; Huang, T.; Qin, G.; Hou, H.; Wang, L.; Tu, H. Biocontrol activity and action mechanism of Paenibacillus polymyxa strain Nl4 against pear Valsa canker caused by Valsa pyri. Front. Microbiol. 2022, 13, 950742. [Google Scholar] [CrossRef] [PubMed]
- Yi, W.; Chen, C.; Gan, X. Polymyxin B1 and E2 from Paenibacillus polymyxa Y–1 for controlling rice bacterial disease. Front. Cell. Infect. Microbiol. 2022, 28, 866357. [Google Scholar] [CrossRef] [PubMed]
- Phi, Q.T.; Park, Y.M.; Ryu, C.M.; Park, S.H.; Ghim, S.Y. Functional identification and expression of indole–3–pyruvate decarboxylase from Paenibacillus polymyxa E681. J. Microbiol. Biotechnol. 2008, 18, 1235–1244. [Google Scholar] [PubMed]
- Sun, H.; Zhang, J.; Liu, W.; E, W.; Wang, X.; Li, H.; Cui, Y.; Zhao, D.; Liu, K.; Du, B.; et al. Identification and combinatorial engineering of indole–3–acetic acid synthetic pathways in Paenibacillus polymyxa. Biotechnol. Biofuels Bioprod. 2022, 15, 81. [Google Scholar] [CrossRef]
- Frank, J.A.; Reich, C.I.; Sharma, S.; Weisbaum, J.S.; Wilson, B.A.; Olsen, G.J. Critical evaluation of two primers commonly used for amplification of bacterial 16S rRNA genes. Appl. Environ. Microbiol. 2008, 74, 2461–2470. [Google Scholar] [CrossRef]
- Rooney, A.P.; Price, N.P.; Ehrhardt, C.; Swezey, J.L.; Bannan, J.D. Phylogeny and molecular taxonomy of the Bacillus subtilis species complex and description of Bacillus subtilis subsp. inaquosorum subsp. nov. Int. J. Syst. Evol. Microbiol. 2009, 59, 2429–2436. [Google Scholar] [CrossRef]
- Tamura, K.; Stecher, G.; Kumar, S. MEGA11: Molecular evolutionary genetics analysis version 11. Mol. Biol. Evol. 2021, 38, 3022–3027. [Google Scholar] [CrossRef]
- Shen, X.X.; Li, Y.; Hittinger, C.T.; Chen, X.X.; Rokas, A. An investigation of irreproducibility in maximum likelihood phylogenetic inference. Nat. Commun. 2020, 11, 6096. [Google Scholar] [CrossRef]
- Lalitha, S. Primer Premier 5. In Biotech Software and Internet Report; Carnegie Institution for Science: Washington, DC, USA, 2000; Volume 1, pp. 270–272. [Google Scholar] [CrossRef]
- Li, F.D.; Yu, Z.N.; He, S.J. Experimental Techniques in Agricultural Microbiology; Chinese Agricultural Press: Beijing, China, 1996; pp. 137–139. [Google Scholar]
- Reasoner, D.J.; Geldreich, E.E. A new medium for the enumeration and subculture of bacteria from potable water. Appl. Environ. Microbiol. 1985, 49, 1–7. [Google Scholar] [CrossRef]
- Li, L.; Guo, N.; Feng, Y.; Duan, M.; Li, C. Effect of Piriformospora indica–induced systemic resistance and basal immunity against Rhizoctonia cerealis and Fusarium graminearum in wheat. Front. Plant Sci. 2022, 13, 836940. [Google Scholar] [CrossRef] [PubMed]

| Phosphorus | Colony Diameter of ZYPP18 (d) (mm) | Transparent Circle (D) (mm) | Transparent Circle/ZYPP18 Diameter (D/d) |
|---|---|---|---|
| Organic phosphorus | 8.3 ± 0.6 | 12.0 ± 0.0 | 1.4 ± 0.1 |
| Inorganic phosphorus | 13.3 ± 1.5 | 20.7 ± 0.6 | 1.6 ± 0.1 |
| Phosphatase | Phosphatase Activity of ZYPP18 Cultured for 3 d (mg/mL−1, 37 °C, 24 h) | Phosphatase Activity of ZYPP18 Cultured for 5 d (mg/mL−1, 37 °C, 24 h) |
|---|---|---|
| Acid phosphatase | 3.014 ± 0.004 | 1.305 ± 0.002 |
| Alkaline phosphatase | 13.846 ± 0.007 | 15.972 ± 0.002 |
| Neutral phosphatase | 0.473 ± 0.001 | 0.461 ± 0.003 |
| Experiments | Control Effect (%) |
|---|---|
| Pot experiments | 56.30 ± 0.55 |
| Field experiments | 65.57 ± 0.22 |
| Antibiotic | Primer | Sequence 5′–3′ |
|---|---|---|
| Polymyxin C | PMXC–F | TACACGGTCTTTGTGGTCATC |
| PMXC–R | GCGTACAGTCCCTTCATCTTC | |
| Polymyxin D | PMXD–F | CTCGCAGGTTTACTTCGTTT |
| PMXD–R | CCAATGCTGGGATTCGTTAT | |
| Fusaricidins | fusA–F | CAAGGATTCGACCGTAGGTG |
| fusA–R | GTAGGGATTATGGCTGACCG | |
| Hydrolysis of proteases | cel44C–F | TTTGGTTACCGCATGGGGTG |
| cel44C–R | TTTCGGACGGAGAGGAGAGTGT | |
| β–Glucanase | PJT–F | TACTAATTGCTCGTATATTTTACCCA |
| PJT–R | TTGCGAATGTGTTCTGGGAACC | |
| Cellulase A | cel5A–F | CTGCTCAACCTGGTCAACG |
| cel5A–R | GCTCAAGGGCATTAGTTCTC | |
| Cellulase B | cel5B–F | CTTGCTGTTGGCATTGAGC |
| cel5B–R | CCTTTGCGAATCCATCTTTC |
Disclaimer/Publisher’s Note: The statements, opinions and data contained in all publications are solely those of the individual author(s) and contributor(s) and not of MDPI and/or the editor(s). MDPI and/or the editor(s) disclaim responsibility for any injury to people or property resulting from any ideas, methods, instructions or products referred to in the content. |
© 2023 by the authors. Licensee MDPI, Basel, Switzerland. This article is an open access article distributed under the terms and conditions of the Creative Commons Attribution (CC BY) license (https://creativecommons.org/licenses/by/4.0/).
Share and Cite
Li, X.; Ma, S.; Meng, Y.; Wei, W.; Peng, C.; Ling, C.; Fan, S.; Liu, Z. Characterization of Antagonistic Bacteria Paenibacillus polymyxa ZYPP18 and the Effects on Plant Growth. Plants 2023, 12, 2504. https://doi.org/10.3390/plants12132504
Li X, Ma S, Meng Y, Wei W, Peng C, Ling C, Fan S, Liu Z. Characterization of Antagonistic Bacteria Paenibacillus polymyxa ZYPP18 and the Effects on Plant Growth. Plants. 2023; 12(13):2504. https://doi.org/10.3390/plants12132504
Chicago/Turabian StyleLi, Xiangying, Sujing Ma, Yuan Meng, Wei Wei, Chen Peng, Chunli Ling, Susu Fan, and Zhenyu Liu. 2023. "Characterization of Antagonistic Bacteria Paenibacillus polymyxa ZYPP18 and the Effects on Plant Growth" Plants 12, no. 13: 2504. https://doi.org/10.3390/plants12132504
APA StyleLi, X., Ma, S., Meng, Y., Wei, W., Peng, C., Ling, C., Fan, S., & Liu, Z. (2023). Characterization of Antagonistic Bacteria Paenibacillus polymyxa ZYPP18 and the Effects on Plant Growth. Plants, 12(13), 2504. https://doi.org/10.3390/plants12132504

